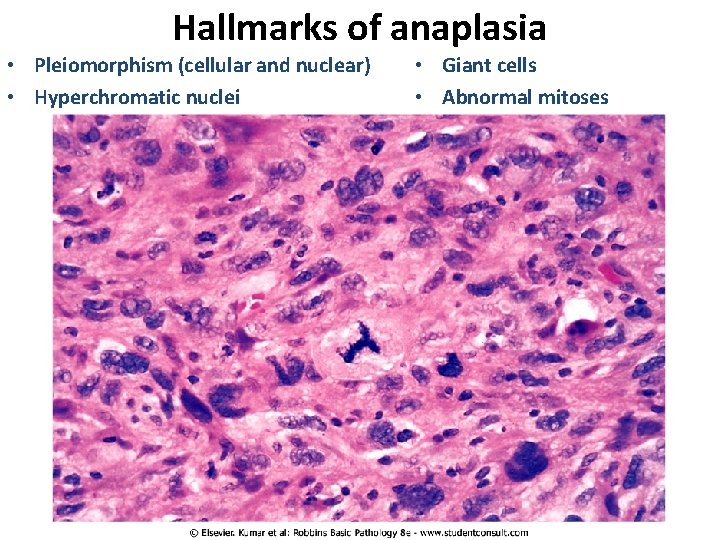
Hallmarks of anaplasia • Pleiomorphism (cellular and nuclear) • Hyperchromatic nuclei • Giant cells Hallmarks of anaplasia • Pleiomorphism (cellular and nuclear) • Hyperchromatic nuclei • Giant cells

Diseases of the Immune System and Neoplastic Disease

- Slides: 40
Diseases of the Immune System and Neoplastic Disease J. Matthew Velkey 454 A Davison, Green Zone, Duke South matt. velkey@duke. edu
Innate vs. adaptive immunity Adaptive Innate – Anti-microbial • • • epithelial barriers phagocytes complement system NK cells Works via immediate recognition of pathogen-specific signals (e. g. bacterial lipopolysaccharide) – Works against pathogens that have evolved to elude innate immunity TWO types of adaptive immunity: • Humoral (antibody-mediated) • Cellular (T-cell-mediated)
Humoral and Cell-mediated Immunity Humoral Immunity Cell-mediated Immunity Involves B-cell production of antibodies that bind antigens resulting in either: Involves T-cell recognition of abnormal antigens on the surface of host cells (indicating viral infection or tumorigenic change) and the killing of infected cells. 1. Neutralization 2. lysis (by the complement system), or 3. phagocytosis and destruction
Cells of the Immune System Lymphocytes – B lymphocytes: antibody production – T helper (CD 4+) cells: “help” or stimulate B-cells to produce antibodies and macrophages to destroy ingested microbes – T cytotoxic (CD 8+) cells: recognize and kill virus-infected or tumorigenic host cells – NK cells: recognize and kill bacteria immediately (part of innate immunity) also can recognize and kill virus-infected or tumorigenic host cells Antigen-presenting cells Capture, process, and present microbial or non-self antigens and present them to T-cells: • Dendritic cells (in lymph nodes and nodules) • Macrophages • B-cells Effector cells Carry out destruction of pathogens and/or infected cells: • • • NK cells Plasma cells (differentiated B-cells) T-helper and T-cytotoxic cells Macrophages Neutrophils, eosinophils, and basophils
Overview of Immune Responses Bacterial response Viral response (and tumors)
Hypersensitivity Immune Reactions Inappropriate or inadequately controlled responses to antigens, caused by: Autoimmunity – reaction of immune system to self Reaction to microbes and viruses – – Persistent infection (e. g. tuberculosis) Immune complex formation (e. g. streptococcal glomerulonephritis) Cross-reactivity with host tissue (e. g. rheumatic heart disease) Cytotoxicity (e. g. viral hepatitis) Reactions against environmental antigens (e. g. pollens, pet dander, bee venom, poison ivy, etc. ) There are FOUR general types of hypersensitivity reactions (type I, type III, and type IV)
Immediate (Type I) Hypersensitivity • “Allergic” reaction • Involves initial activation of TH 2 cells and production of Ig. E from B-cells • Ig. E binds to mast cells • Secondary exposure of Ig. E-coated mast cells to antigen elicits degranulation
Products released by mast cells elicit symptoms associated with allergies Immediate reaction (histamine, prostaglandin, and leukotrienes): Vasodilation Vascular leakage (edema) Smooth muscle spasm Late-phase reaction (leukotrienes and other cytokines): Leukocyte infiltration (particularly neutrophils and eosinophils) Epithelial damage Bronchospasm Clinical manifestations may be local or systemic and may range from mild (sinusitis) to severe (anaphylactic shock). Also, may be acute or CHRONIC (e. g. asthma)
Type II hypersensitivity Caused by antibodies directed against antigens on cell surfaces or other tissue components Opsonization: Ab targets cells for direct destruction by phagocytes or complement system (e. g. thrombocytopenia) Inflammation and tissue injury: via activation of leukocytes & complement system (e. g. streptococcal rheumatic heart disease) Antibody-mediated cellular dysfunction: Bound Abs may interfere with cell function (e. g. myasthenia gravis) or may cause HYPERfunction (e. g. Graves disease)
Type III Hypersensitivity immune complex diseases Phases of disease: 1. Formation of Ag-Ab complexes in the circulation 2. Deposition of immune complexes in various tissues 3. Inflammatory reaction and destruction of host tissues Examples include: – – – Systemic lupus erythematosus Streptococcal glomerulonephritis Polyarteritis nodosa Reactive arthritis “Serum sickness” (reaction to foreign serum)
Type IV Hypersensitivity • Delayed-type hypersensitivity (e. g. tuberculin reaction, dermatitis) – TH 1 cells presented with antigen release IFN-γ and other cytokines causing inflammation and tissue injury • Direct cell cytotoxicity (e. g. T 1 DM, MS, RA) – T-cytotoxic cells react to antigens displayed by host cells
Graft Rejection While it is the host that usually rejects the graft, note that the graft can “reject” the host (as in graft vs. host disease) – this happens when T-cells from the graft react against the host tissues
Autoimmunity: a loss of self-tolerance Tolerance = unresponsiveness to self-antigens Central tolerance: deletion of self-reactive B and T-cells during their development Peripheral tolerance: squelching of selfreactive cells: – Anergy: Ag presentation without costimulatory B 7 signal – Suppression: T reg cells secrete suppressive cytokines (IL-10) that dampen TH and TC responses – Apoptosis: T-cells activated by selfantigens usually activate apoptosis pathways
Mechanisms of Autoimmunity • Genetic susceptibility: genetic variations in HLA (human leukocyte antigen) alleles linked to several autoimmune diseases • Stimulation by infections (e. g. streptococci or Klebsiella) or tissue injury (release of self-antigens)
Neoplasia: “new growth” "an abnormal mass of tissue the growth of which exceeds and is uncoordinated with that of the normal tissues and persists in the same excessive manner after the cessation of the stimuli which evoked the change. “ (R. A. Willis) 5 Aspects of cancer to consider: 1. Nomenclature 2. Characteristics 3. Epidemiology 4. Carcinogenesis 5. Clinical aspects
Nomenclature Benign: -oma Malignant: -sarcoma or -carcinoma
Characteristics to consider: differentiation vs. anaplasia Benign tumors usually consist of differentiated cells, e. g. lipomas (fat) and leiomyomas (smooth muscle) Malignant tumors can range from being well-differentiated to undifferentiated or anaplastic Well-differentiated squamous cell carcinoma Anaplastic rhabdomyosarcoma
Hallmarks of anaplasia • Pleiomorphism (cellular and nuclear) • Hyperchromatic nuclei • Giant cells • Abnormal mitoses
Other characteristics to consider: • Rate of growth – benign tumors tend to grow slowly whereas malignant tumors grow more rapidly • Local invasion – benign lesions are usually (but not always) encapsulated whereas cancers grow by progressive infiltration into surrounding tissue • Metastasis – development of secondary implants in remote tissue that is discontinuous with the primary tumor. – Spread by seeding occurs when tumors invade a space or cavity (e. g. peritoneum, pleura, cerebral ventricles, etc. ) – Lymphatic spread occurs by tumor cells (usually –carcinomas) traveling via lymph vessels – Hematogenous spread occurs by tumor cells (usually –sarcomas) traveling via blood vessels. Favored sites are lung and liver
Benign vs. Malignant: a summary
Cancer Incidence ~1. 4 M new cancer cases in 2006: ~565 k cancer deaths in 2006: • ~30% prostate(♂) /breast (♀) • ~12% lung • 10% colon • ~30% lung • 9% prostate / 15% breast • 10% colon
Factors contributing to carcinogenesis Age - In general, the frequency of cancer increases with age. Most cancer deaths occur between ages 55 and 75. Heredity - genetic predisposition to cancer can give rise to hereditary cancers: • Inherited Cancer Syndromes – inheritance of a single mutant gene • Familial Cancers – observed familial clustering but NOT associated with any specific markers • Inherited Recessive Syndrome – associated with defective DNA repair gene Preneoplasia - recognized tissue insults that can progress to cancer (e. g. liver cirrhosis, bronchial dysplasia, endometrial hyperplasia, esophageal dysplasia, leukoplakia) Environmental Agents – exposure to agents that either damage cells or DNA increases cancer risk (chemicals, radiation, pathogens, biologically active compounds)
Carcinogenesis Hallmarks of cancer: • • • Self-sufficiency in growth signals Insensitivity to anti-proliferative signals Evasion of apoptosis Limitless replicative potential Sustained angiogenesis Tissue invasion Mostly caused by mutations in genes that regulate these processes. Proto-oncogene: genes that normally promote cell proliferation Oncogene: mutant version of protooncogene that can function autonomously to promote growth
Self-sufficient Growth Signals Alterations in any aspect of growth factor pathways can cause cells to proliferate uncontrollably (e. g. the FGF-RAS-MAP kinase pathway): • • Growth factors themselves Growth factor receptors Signal transduction proteins Nuclear transcription factors
Self-sufficient Growth Signals Alterations in cell-cycle control proteins can lead to unchecked proliferation: • Cyclins • Cyclin-depedent kinases • CDK inhibitors
Insensitivity to Growth Inhibition: the RB gene, a tumor suppressor The RB gene normally controls the G 1 -to-S transition – in its active form, RB is hypophosphorylated and prevents expression of genes necessary for DNA replication, so cells are arrested in G 1. Mutations or alterations anywhere in the RB pathway can release this brake.
Insensitivity to Growth Inhibition: the p 53 gene, another tumor suppressor p 53 normally monitors cellular stress and DNA damage. In the presence of damage, p 53 arrests the cell to allow for repair. If repair is unsuccessful, p 53 elicits apoptosis. Mutations or alterations in this pathway can lead to dysfunction of p 53 and unchecked growth.
Insensitivity to Growth Inhibition: the APC gene, yet another tumor suppressor APC normally inhibits the activity of β-catenin by targeting it for destruction. Alterations in APC or other aspects of the WNT pathway can lead to a release of this brake.
Evasion of apoptosis • Reduced expression of apoptosis signaling receptors (e. g. Fas) • Reduced expression of apoptosis signal transduction components (e. g. FADD) • Reduced expression of apoptosis effectors (e. g. caspase 8) or co-factors (e. g. APAF-1) • Upregulation of anti-apoptotic genes (e. g. BCL 2) • Reduced p 53 -pathway activity
Limitless Replication Chromosomes are capped by telomeres of finite length that shorten with each round of replication. Eventually, the telomeres become shortened enough to lead to senescence. Normal mature cells do not express telomerase (the enzyme required to maintain telomere length), but many tumor cells reactivate telomerase and therefore can grow indefinitely.
Sustained Angiogenesis Vascularization essential for the growth of solid tumors. As tumors grow, they become hypoxic and release factors that cause blood vessels to grow into them - this can be further augmented by loss of function of regulatory components that regulate the release of pro-angiogenic factors (e. g. reduced activity of VHL, which normally antagonizes HIF induction of VEGF expression) p 53 activity normally leads to expression of anti-angiogenesis factors such as thrombospondin-1; loss of p 53 will release this brake. Also, many tumors secrete extra-cellular matrix proteases that further enable and promote angiogenesis.
Metastasis • Invasion and passage through basement membrane • Migration through extracellular matrix • Migration into vessels (intravasation) • Adhesion to vascular endothelium (usually in lung or liver) • Extravasation and migration into tissue • Establishment and growth at new site
Effects on the patient • Impingement on nearby structures can alter their function (e. g. nerve compression, blockage of glandular ducts, dyspnea, dysphagia, etc. ) • Internal bleeding or infarction • Paraneoplastic syndromes – Hypercalcemia due to PTH production by tumor cells – Cushing syndrome due to ACTH production by tumor – Hypercoagulability (production of coagulation factors by tumor? ) • Cachexia: progressive loss of body fat and lean body mass accompanied by profound weakness and anemia – Likely mediated by TNF and other factors – Patients often have reduced appetite, but basal metabolic rate remains high in spite of starvation – Lipid mobilization is compromised so muscle wasting occurs – Only known “cure” is to remove the tumor – Estimated that ~33% of cancer deaths is due to cachexia
Staging Of Cancer • Standardized way of classifying disease progression • Critically important for: – Prognosis and treatment – Comparison to literature
Staging of Cancer • Stage is based on: – Size of the primary tumor and/or extent of local invasion – Extent of spread to regional lymph nodes – Presence or absence of distant metastases
Staging of Cancer Two major systems: • UICC: Union Internationale Contre Cancer • AJCC: American Joint Committee on Cancer Staging
UICC: TNM System • T: Primary tumor size – T 0 (in situ) to T 4 (very large) • N: Lymph node involvement: – N 0 (no nodal involvement) to N 3 (multiple involved lymph nodes) • M: Distant metastases, – M 0 (no distant metastases) to M 1 and M 2 (multiple metastases)
AJCC: STAGE I - IV • Stage I – Smallest tumors. • Stage II, III – Larger tumors, more local spread. • Stage IV – Metastases
“Stage Grouping” Each cancer has a table that “groups” TNM possibilities into the 4 AJCC stages AJCC UICC Tumors with similar AJCC stage have similar survival
Cancer stage is critical for determining prognosis and therapy Stage is usually the single most important predictor of survival